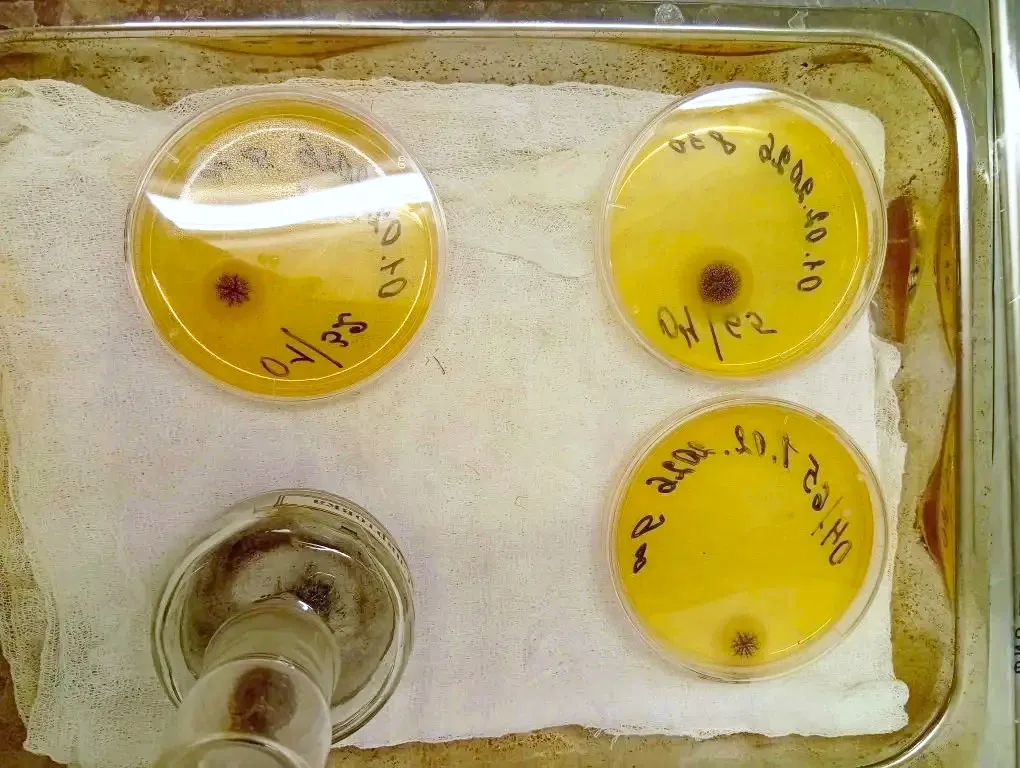

Специалисты бактериологической лаборатории Ессентукского филиала ФБУ «Северо-Кавказский ЦСМ», согласно программе производственного контроля, проводят исследования пищевой продукции, в соответствии с требованиями технического регламента Таможенного союза ТР ТС 021/2011 «О безопасности пищевой продукции», на показатели «дрожжи», «плесени».
Отсутствие микроорганизмов порчи — дрожжей и плесеней — является одним из показателей микробиологической безопасности и пищевой ценности продукта.
Сверхнормативное присутствие дрожжей и плесени в продуктах питания способствует поступлению и накоплению в организме человека токсичных веществ и вызывает нарушение обмена веществ, аллергические реакции, расстройство функций желудочно-кишечного тракта.
Дрожжи — одноклеточные организмы овальной, продолговатой или округлой формы, по типу дыхания аэробы. Размножаются делением, почкованием или спорами. Некоторые виды дрожжей вызывают порчу и прогорклость пищевых продуктов в процессе их хранения, а также они попадают в продукцию при несоблюдении санитарных требований.
Лабораторные исследования осуществляются микробиологическим методом, который позволяет выявить и определить количество дрожжей и плесеней в пищевых продуктах.
Прямой задачей современных пищевых технологов является защита пищевых продуктов от различных видов порчи, для чего необходимо контролировать микрофлору продуктов, предотвращая контаминацию и препятствуя росту дрожжей и плесеней.